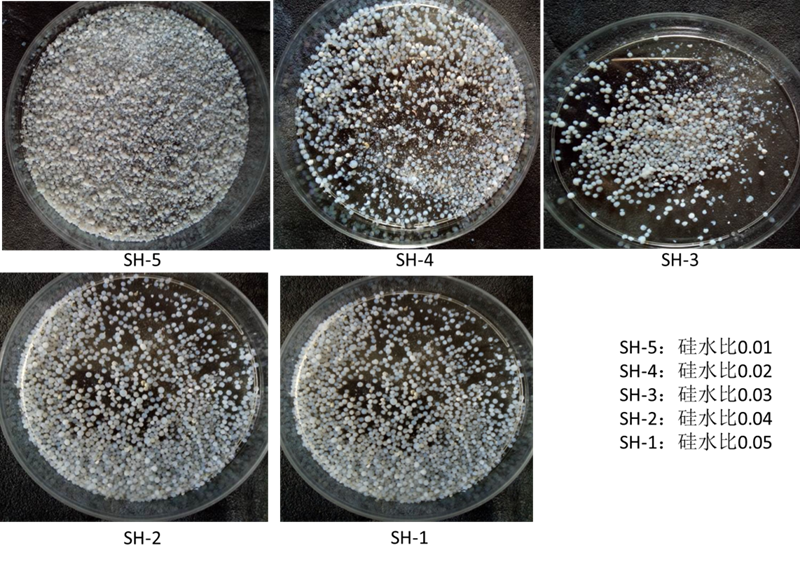

高绝热球状二氧化硅气凝胶填料的制备毕业论文
2020-04-08 12:45:58
摘 要
本文主要探究高绝热球状二氧化硅气凝胶填料的制备方案并对产品进行测试,实验以廉价的硅溶胶为硅源,氟化铵/氨水的混合液作为催化剂,利用滴落法制备毫米级二氧化硅气凝胶球。将溶胶调节PH后用蠕动泵均匀滴落在自制的憎水表面上,经过震动和滚动,形成良好的凝胶球;凝胶以后,将湿凝胶球放入乙醇溶液中老化,经索氏抽提进行溶剂置换后使用三甲基氯硅烷/正己烷作为改性试剂进行疏水改性,常压干燥得到二氧化硅气凝胶球。本文研究溶胶-凝胶工艺参数(硅水比、温度、PH)对凝胶时间的影响以及乙醇添加量、硅水比对气凝胶球性能的影响,并确定合适的生产工艺,制备高性能的球状二氧化硅气凝胶填料。
得出如下结论:以硅溶胶作为硅源,利用硅溶胶-正硅酸四乙酯作共前驱体,采用酸碱两步催化溶胶-凝胶法制备湿凝胶,利用球滴法成型,通过常压干燥工艺可制备得到球状二氧化硅气凝胶填料,且具有低成本、高效率、产品高性能等特点。
关键词:球状二氧化硅气凝胶填料;常压制备;震动憎水表面;理化性能
Abstract
This article focuses on the preparation of high-insulation spherical silica aerogel fillers and testing of products. Experiments using low-cost silica sol as a silicon source and a mixture of ammonium fluoride/ammonia as a catalyst to prepare millimetric silica aerogel balls by dripping. After adjusting the pH of the sol, the peristaltic pump was evenly dropped on the surface of the self-made hydrophobic water. By shaking and rolling, a good gel ball is formed. After gelation, the wet gel balls are aged in ethanol solution. Solvent extraction after soxhlet extraction, trimethyl chlorosilane/n-hexane as modification reagent for hydrophobic modification, and dried under atmospheric pressure to obtain silica aerogel balls. In this paper, the effects of sol-gel process parameters (silicon-water ratio, temperature, and pH) on the gelation time, and the effects of the amount of ethanol added and the ratio of silicon to water on the aerogel spheres are studied. And determine a suitable preparation scheme to prepare high-performance spherical silica aerogel fillers.
Draw the following conclusion: Using silica sol as silicon source and silica sol-tetraethyl orthosilicate as co-precursors .Wet gels are prepared using a two-step acid-base catalyzed sol-gel process. Spherical silica aerogel fillers can be prepared by a spherical pressure drop method through an atmospheric drying process. And it has low cost, high efficiency, high performance and other features.
Key words:Spherical silica aerogel filler;Atmospheric pressure preparation;Vibrating hydrophobic surface;Physical and chemical properties
目录
第一章 绪论 1
1.1二氧化硅气凝胶概述 1
1.2二氧化硅气凝胶球的发展及应用 1
1.3二氧化硅气凝胶球的制备机理 2
1.4本课题的选题意义及研究内容 5
第二章 实验过程 6
2.1实验药品 6
2.2实验仪器及设备 6
2.3样品制备过程 7
2.3.1湿凝胶球的制备 7
2.3.2气凝胶球的制备 7
2.4性能表征 8
2.4.1凝胶时间记录 8
2.4.2振实密度测试 8
2.4.3粒径分布和强度的检测 8
2.4.4热学性能测试 8
第三章 结果分析 10
3.1凝胶温度/PH—凝胶时间 10
3.2硅水比—凝胶时间/密度 11
3.3粒径分布和表观形貌 11
3.4 SiO2气凝胶的红外光谱分析 14
3.5 SiO2气凝胶的TG-DTA分析 16
3.6 SiO2气凝胶的绝热性能分析 16
3.7 SiO2气凝胶球的物性分析 18
第四章 结论与展望 20
4.1结论 20
4.2展望 20
参考文献 21
致谢 22
第一章 绪论
1.1二氧化硅气凝胶概述
二氧化硅气凝胶是一种由纳米量级颗粒相互聚合形成的具有连续三维网络结构的固体材料。相比于微米、毫米级孔径的多孔材料,其纳米级的孔洞结构使得二氧化硅气凝胶具有低密度、高孔隙率、高比表面积、低热导率等优良特性。Si02气凝胶是由Si-O-Si链高度交联的湿凝胶经干燥后得到的以气体为介质的高分散体系,由于其优越的特性,二氧化硅气凝胶是科学和技术应用的潜在应用材料,如环境清理和保护、热核聚变反应的惯性约束核聚变(ICF)目标、高效的催化剂和催化剂载体、太阳能系统的高效绝热体,冰箱,保温瓶,建筑,航空和航空航天领域和其他领域。其广阔的发展应用前景使SiO2气凝胶的研发制备受到越来越多关注。[1-3]
本文主要研究高绝热球状二氧化硅气凝胶填料的制备,气凝胶在高温下仍能保持其结构的稳定,且其特殊的结构可降低热量的传导、传递,具有较低的导热系数,在高绝热材料领域有着广阔前景。
1.2二氧化硅气凝胶球的发展及应用
SiO2气凝胶的研发应用一直备受关注。目前,以正硅酸四乙酯和硅溶胶作为硅源,通过超临界干燥工艺制备得到的SiO2气凝胶多为尺寸不一的不规则块体,在实际应用中常出现填充不均匀以及使用效率低等问题,且超临界干燥工艺实验周期长、产量低、成本高等缺点限制了气凝胶的工业化生产。针对SiO2气凝胶的生产工艺和目前气凝胶产品存在的缺陷,我们希望改进SiO2气凝胶生产工艺,实习低成本、高效率的工业化生产。球状气凝胶相较于块体材料具有很显著的优异性,球体的结构特性决定了球状气凝胶具有更高的强度、流动性,且作为填充材料,其填充效果更好,方便回收利用。因此,外形规则且粒径可控的SiO2气凝胶球对气凝胶的应用领域拓展有着重要意义,也对制备工艺提出了新的要求。
作为材料领域研究的热点,Si02气凝胶的制备及应用受到巨大的关注,其产品的生产工艺也在不断研发改进。近年来,针对气凝胶的生产工艺改进和产品性能优化,国内外专家学者开展了大量研究工作,从气凝胶的制备成型、结构尺寸控制、性能检测、生产工艺优化等方面着手,在硅源、前驱体、溶胶-凝胶过程工艺参数、成型工艺、凝胶老化工艺、溶剂置换和表面改性工艺以及干燥工艺等方面取得了重大突破。[4]
目前,SiO2气凝胶球的成型工艺主要有:滴落法和模具法。李红伟[4]等通过滴落法制备毫米级二氧化硅气凝胶球,采用二氧化硅气凝胶粉末自制疏水平台,将水玻璃(模数n=1.8~2.3)离子交换制备出溶胶,调节pH 值后分散滴落于平台上,可保持为毫米级溶胶球,经溶胶-凝胶反应后形成湿凝胶球。二氧化硅气凝胶球的粒径与滴加的针头孔径有关,粒径为1-2mm的SiO2气凝胶球由于受重力影响较小,在表面张力的作用下保持较高球形度。
Pradip B. Sarawade[5]等报道了一种微米尺寸的二氧化硅气凝胶球的合成与表征,采用滴落法将硅溶胶调节PH值后逐滴分散在煤油作为上层,氨水溶液作为下层的反应容器内,硅溶胶接触氨水凝胶形成微米级的凝胶球,凝胶时间少于1min,最终产品密度最低可达0.364g/cm3,孔隙率可达85.23%;
Huijun Yu[6]等以疏水改性剂甲基三乙氧基硅烷和正硅酸四乙酯为前驱体,一种聚四氟乙烯容器作为模具制备出厘米级的二氧化硅气凝胶球,抗裂性能良好,同时达到低密度、高孔隙率的要求。
在球滴法中,SiO2气凝胶的成球通过逐滴滴落的形式形成溶胶液滴进而成型。溶胶小球滴在超疏水界面上发生溶胶-凝胶反应生成气凝胶球,效率低,同时为防止溶胶液滴汇聚成大液滴,需使用较多氨水加快溶胶-凝胶反应,制备出的凝胶小球的外表面容易出现乳白色而非浅蓝色透明球体,SiO2气凝胶球产品的品质下降,且制备出的产品容易附着在表面上,球形度无法保证。在模具法中,使用聚四氟乙烯容器作为模具,生产效率低且成本高,且由于缩聚反应制备出的醇凝胶小球容易表面开裂,无法保证强度,凝胶成球工艺有待进一步改进。
目前二氧化硅气凝胶材料由于受制备工艺制约而无法实现工业化生产。由于在实际应用中气凝胶形状会影响产品强度、填充效果及产品的回收利用,为了实现SiO2气凝胶的工业化生产和实际应用,球状SiO2气凝胶的制备成为主要研究内容。为实现气凝胶的推广应用,粒径可控、较高球形度成为了气凝胶产品另一个性能指标,也对球状SiO2气凝胶生产制备工艺的优化提出了新的要求。[7]
通常SiO2气凝胶材料的热稳定性较强,在1300℃下仍能保持结构稳定,耐高温,且其纳米开孔结构可很大程度上降低固态传导、气态传导以及红外热辐射,具有极低的热导率,常在保温隔热领域中作为填料使用。同时SiO2气凝胶还是密度最小的固态材料,与传统隔热材料如泡沫板等多孔材料相比,其具有更轻的质量、更小的体积、可耐更高的温度,这种特性使得SiO2气凝胶在绝热领域有更多应用,包括输热管道、LNG保温、气凝胶涂料(保温、疏水等)、太阳能系统、汽车隔热材料、建筑材料、日常生活以及军工领域等等。
1.3二氧化硅气凝胶球的制备机理
SiO2气凝胶的制备通常分为三个个阶段,第一阶段是溶胶—凝胶阶段,第二阶段是凝胶老化、凝胶孔隙的溶剂置换以及表面改性,第三阶段是干燥阶段。以硅溶胶为前驱体常压干燥制备SiO2气凝胶工艺流程如图1. 1所示。
图1.1气凝胶工艺流程图
(1)溶胶—凝胶原理
本文制备SiO2气凝胶所采用溶胶-凝胶法就是硅溶胶作硅源,硅溶胶和正硅酸四乙酯作共前驱体,以乙醇为溶剂与一定量水混合,在一定工艺条件下进行水解、缩合化学反应,溶胶中活性SiO2单体或多聚体缓慢聚合,形成三维空间网络结构的醇凝胶,凝胶网络间充满了失去流动性的溶剂,形成凝胶。其过程主要分为两步:一是原料的水解;二是水解后的形成的活性单体聚合最终生成凝胶。因其方法简洁,成本低,且胶粒在溶剂-凝胶体系中分散均匀,成为SiO2气凝胶制备的常用工艺方法。[8]
硅溶胶化学式为其化学分子式为mSiO2·nH2O,通常是粒径为纳米级的无定形二氧化硅在水中形成的分散体系,即二氧化硅水溶胶,一般是以氧化钠或氨作稳定剂的碱性硅溶胶。硅溶胶中通过添加正硅酸四乙酯、乙醇、催化剂、去离子水,调节PH,使其水解形成活性单体SiO2,并最终通过调整PH值,活性单体通过发生缩聚反应最终形成内部充斥着溶剂的湿凝胶。[9-10]缩聚反应如图1.2化学反应式所示。
图1. 2 缩聚反应化学反应式
(2)凝胶的陈化工艺
SiO2气凝胶的老化,使用乙醇溶剂对湿凝胶球进行老化,补充和稳固凝胶的三维网络结构。
SiO2气凝胶的溶剂置换,使用异丙醇作为置换溶剂置换出湿凝胶球中的乙醇溶剂,再使用正己烷作为置换溶剂利用索氏抽提进行溶剂置换,低表面张力的正己烷溶剂可保证和改善凝胶的结构和强度。
SiO2气凝胶的表面改性,未被修饰的二氧化硅湿凝胶表面覆盖有对水分敏感的羟基(—OH)。通过表面改性剂作用形成O-Si-CH3基团对凝胶表面改性进而改变二氧化硅网络的表面化学性。[11]
(3)常压干燥工艺
经过陈化处理后的湿凝胶球最终需通过干燥制得SiO2气凝胶,干燥过程中湿凝胶球体孔隙中的溶剂被空气所取代,同时凝胶球的纳米开孔结构保持稳定不被破坏,最终形成具有优良特性的SiO2气凝胶。[12]
目前,超临界干燥工艺作为SiO2气凝胶的主要干燥工艺被实验室应用,与常压干燥相比,由于在超临界压力下几乎为零的表面张力,可避免由干燥过程中溶剂快速蒸发的外力以及与液体流动相关的表面张力的引发SiO2气凝胶纳米孔洞的收缩塌陷、颗粒聚集,但该工艺存在实验周期长、实验环境要求高、工艺复杂、成本高、干燥效率低等缺点。本文采用低成本且高效的常压干燥工艺,通过凝胶老化、溶剂置换,将凝胶球孔隙中的乙醇、水溶剂置换为正己烷,正己烷低表面张力可降低毛细管力,同时改变凝胶体系成分以增强网络骨架强度,最后通过三甲基氯硅烷/正己烷进行疏水改性,避免SiO2胶体颗粒表面亲水基团羟基(—OH)发生脱水缩合反应造成凝胶球的收缩,常压干燥过程中干燥温度、时间等工艺参数也是影响SiO2气凝胶性能和成品率的重要因素。
1.4本课题的选题意义及研究内容
针对高绝热球状二氧化硅气凝胶填料性能指标要求,如表1.1所示,本文以硅溶胶为硅源,同时以硅溶胶并引入少量正硅酸四乙酯(TEOS)作为共前驱体,采用蠕动泵滴落法以及振动盘振动制备毫米级别的疏水性二氧化硅气凝胶球,通过预制疏水振动盘,使得溶胶逐滴滴落在疏水振动盘的螺旋通道内,保证溶胶在凝胶过程中保持震动状态,凝胶之后,凝胶球能够在螺旋通道内滚动连续出料,再通过凝胶老化、溶剂置换、表面疏水改性等基本工艺对湿凝胶进行后处理,才用常压干燥工艺制备SiO2气凝胶球 [13]。 本文侧重研究凝胶球的制备工艺和研究气凝胶球的成球工艺以及气凝胶球粒径大小和分布的影响因素,同时探讨凝胶体系水硅比、TEOS/ETOH体积比对气凝胶球性能的影响,最终对球状SiO2气凝胶的性能评价并表征。
目前,二氧化硅气凝胶球的制备多以正硅酸四乙酯作硅源,原料试剂成本高且较难获取,无法适应产业化大规模生产,硅溶胶具有廉价、易获取的特点且同样可以提供SiO2,可利用硅溶胶作硅源制备二氧化硅气凝胶;且应用于市场的二氧化硅气凝胶产品多为不规则块状,实际应用受到限制,成型工艺有待优化以制备出粒径可控的球状气凝胶;凝胶工艺也导致气凝胶无法实现连续生产,生产制备效率极低;实验室常用的超临界干燥工艺由于受到设备昂贵、周期长、实验环境要求高、工艺复杂等要求无法实现推广应用,常压干燥工艺有待研究改进。本文希望探究合适的生产工艺,提高二氧化硅气凝胶球性能,降低生产成本,优化生产工艺,实现工业化高效连续生产。
表1.1二氧化硅气凝胶球填料性能指标
性能表征 | 指标参数 | 目标参数 |
平均粒径 | 0-10mm | 2-4mm |
振实密度 | 0.003-0.500g/cm-3 | <0.200 g/cm-3 |
强度 | 小球无明显破碎 | 小球无明显破碎 |
孔隙率 | >60% | >90% |
导热系数 热稳定性 | <0.23W/m·k 升温至1000℃,失重率<12% | <0.10 W/m·k <10% |
第二章 实验过程
2.1实验药品
表2.1实验所用主要试剂
名称 | 分子式 | 规格/型号 | 生产厂家 |
硅溶胶 | — | JN-40 | 上海汇平化工有限公司 |
正硅酸四乙酯 | C8H20O4Si | AR | 国药集团化学试剂有限公司 |
无水乙醇 | C2H6O | AR | 国药集团化学试剂有限公司 |
盐酸 | HCl | AR | 中国平煤神马集团开封东大化工有限公司 |
氟化氨 | NH4F | AR | 国药集团化学试剂有限公司 |
异丙醇 | C3H8O | AR | 国药集团化学试剂有限公司 |
正己烷 | C6H14 | AR | 国药集团化学试剂有限公司 |
三甲基氯硅烷 | C3H9ClSi | CP | 国药集团化学试剂有限公司 |
氨水 | NH3 | AR | 国药集团化学试剂有限公司 |
气相纳米二氧化硅 | SiO2 | R974 | 绍兴市利洁化工有限公司 |
疏水涂料 | — | Neverwet | 美国Ross Nanotechnologies |
2.2实验仪器及设备
表2.2实验仪器及设备
仪器名称 | 生产厂家 | 仪器型号 |
集热式恒温加热磁力搅拌器 | 邦西仪器科技(上海)有限公司 | DF-101S |
注射泵 | 欣卡电子有限公司 | — |
蠕动泵 | 保定申辰泵业有限公司 | LabV1 |
振动盘 | 东莞市坤昌五金机械有限公司 | KCZ010 |
索氏抽提装置 | 上海魅宇仪器设备有限公司 | 250ml索氏提取器 |
傅里叶变换红外测试仪 | 美国THERMOELECTRONSCIENTIFICINSTRUMENTS | Nicolet6700 |
电子分析天平 | 上海卓精电子科技有限公司 | BSM分析天平 |
同步热分析仪 | 德国耐驰仪器公司 | STA449F3 |
注:疏水振动盘即在振动盘上喷涂一层Never wet疏水涂料,并且在表面上平铺一层疏水气相二氧化硅。
2.3样品制备过程
2.3.1湿凝胶球的制备
(1)催化剂的制备:量取100ml去离子水置于烧杯中,称量20.50g氨水(分析纯),再加入1.85g的氟化铵试剂,搅拌均匀后即得到氟化铵与氨水的混合溶液。
(2)量取适量硅溶胶JN-40(SiO2含量为40%,PH=9),添加少量正硅酸四乙酯和乙醇,离子水稀释后,用10%的盐酸调节反应体系PH为2,静置水解24h后,添加去离子水稀释,定为组份A。
以上是毕业论文大纲或资料介绍,该课题完整毕业论文、开题报告、任务书、程序设计、图纸设计等资料请添加微信获取,微信号:bysjorg。
相关图片展示:

您可能感兴趣的文章
- 利用污泥和低质粉煤灰制备高强度陶粒外文翻译资料
- 注蒸汽井中硅含量对水泥石抗压强度的影响外文翻译资料
- 碳纳米管和二氧化锰纳米粒子修饰的少层石墨烯在高性能超级电容器中的应用外文翻译资料
- 高能MnO2纳米线/石墨烯和石墨烯不对称电化学电容器外文翻译资料
- 影响立式辊磨机性能的操作参数外文翻译资料
- 水泥行业立式辊磨机及其性能参数研究进展外文翻译资料
- 立式辊磨机遇滚磨机基于能量的比较外文翻译资料
- 一种工作在500℃以下用于固体氧化物燃料电池的铌和钽共掺杂钙钛矿阴极外文翻译资料
- 层状钙钛矿A位缺陷的理解: 促进质子陶瓷电化学电池水氧化和氧还原的双反应动力学外文翻译资料
- 基于细菌纤维素/木质素的柔性高石墨化碳气凝胶: 无催化剂合成及其在储能装置中的应用外文翻译资料


